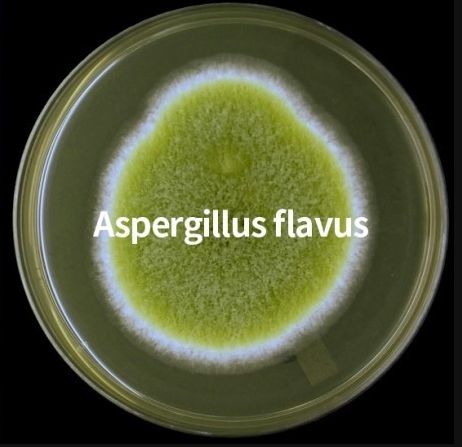
雪卡毒素(深海魚毒素雪卡毒素)-添財網(wǎng)

雪卡毒素(深海魚毒素雪卡毒素)
熱衷養(yǎng)綠毛的壹讀君 | 彤 子
10月5日,黑龍江省雞西市發(fā)生了一起9人聚餐8人死亡的慘劇,另外1人仍在搶救中。
當?shù)毓矙C關(guān)對現(xiàn)場提取物進行了檢測,未查出氰化物、農(nóng)藥類、鼠藥類等有毒物質(zhì),故案件已排除人為投毒可能。
醫(yī)院檢測發(fā)現(xiàn)食物中黃曲霉毒素嚴重超標。調(diào)查得知,被害者聚餐期間共同食用了自制酸湯子,且酸湯子的食材已在冰箱冷凍了一年之久。

酸湯子:是用玉米水磨發(fā)酵后做的一種粗面條樣的主食。
有關(guān)部門提示:受黃曲霉菌污染的糧食及食品不能食用。

兩天后,雞西流行病學(xué)調(diào)查和疾控中心采樣結(jié)果顯示:玉米面中檢出高濃度的米酵酸菌。案件再次定性為由米酵菌酸引發(fā)的食物中毒事件。

此次事件的真兇到底是黃曲霉毒素還是米酵菌酸呢?這兩樣都是致人死地的高手!
食物里的“定時炸彈”
自然界中廣泛分布著各種真菌,它們隨風(fēng)飄揚到世界的各個角落,把人類的食物當做營養(yǎng)豐富的培養(yǎng)基。其中,黃曲霉菌常在糧食 (玉米、小麥、大米) 、油料 (食用油、油料餅粕) 、堅果 (花生等) 落地生根、生長繁殖,同時還會“順手”產(chǎn)生點超級毒素——黃曲霉毒素(Aflatoxin) 。
黃曲霉菌
注:除了黃曲霉菌,寄生曲霉菌(A.parasiticus)和毛霉、青霉、鐮孢曲霉等其他真菌也能產(chǎn)生黃曲霉毒素。
黃曲霉毒素有多毒?一粒大米重量(20mg)的黃曲霉素就能導(dǎo)致一個成年人死亡,其毒性是氰化鉀的10倍,砒霜的68倍。

氰化鉀,有苦杏仁氣味,柯南劇情中常用劇毒
1960年黃曲霉毒素在數(shù)月內(nèi)干掉了英國南部地區(qū)的十萬只火雞,制造了神秘的“火雞X病”。后來人們查到了原因,“兇手”就是飼料中霉變花生粉產(chǎn)生的黃曲霉毒素,用這種霉變花生粉投喂大白鼠可誘發(fā)其患肝癌。
不止大白鼠,人類在黃曲霉毒素的毒害下也能致死、致癌。1974年印度由于雨水過多,導(dǎo)致玉米嚴重霉變,造成當?shù)?97人中毒,106人死亡,幸存者的肝臟出現(xiàn)不同程度損傷,體重減輕,誘發(fā)肝癌等。
1993年,世界衛(wèi)生組織癌癥研究機構(gòu)把黃曲霉毒素劃定為一類致癌物。
黃曲霉毒素是已知致癌物質(zhì)中最強的致癌物質(zhì)之一,其致癌力是腌制食品的700倍,是亞硝胺的75倍,是苯并芘(燒烤)的4000倍。
黃曲霉毒素主要通過食物攝入人體,經(jīng)消化道吸收,由肝臟的P450酶“激活”,所以大部分黃曲霉毒素會聚集在肝臟 (少量分布在腎臟、血液、肌肉和脂肪中)導(dǎo)致肝癌。
即便沒有導(dǎo)致癌癥,殘存在人體的黃曲霉毒素還能使染色體畸變、斷裂,部分染色體缺失,最終引發(fā)人體基因突變,再進一步發(fā)展為癌癥。
更討厭的是,這種又毒又致癌的黃曲霉毒素擅耐高溫,在268℃才能分解,對一般的烹調(diào)加熱完全“免疫”。
然而自然界中不止有致病的真菌,還有病菌,其中有種讓人上吐下瀉的病菌堪稱食物中毒界的“扛把子”,就是前面再次定性的毒性物質(zhì)米酵菌酸的“生產(chǎn)者”。
食物中毒界的“扛把子”
在中國有一種比較普遍的食源性致病菌——唐菖蒲伯克霍爾德菌椰毒致病變種,簡稱BGC。
由于BGC對生長環(huán)境要求不高,可在玉米面、米粉、銀耳、木耳等有機化合物上生長,能在適宜條件下,短時間產(chǎn)生大量米酵菌酸(bongkrekic acid),從而引起食物中毒和死亡。

米酵菌酸
BGC在我國經(jīng)歷過多次“姓名變更”:產(chǎn)毒黃桿菌→酵米面黃桿菌→酵米面假單胞菌→ 椰毒假單胞菌酵米面亞種→ 唐菖蒲伯克霍爾德菌椰毒致病變種(BGC)。
早在1977年中國學(xué)者就在酵米面中毒食品中發(fā)現(xiàn)并分離出BGC。BGC在我國引起的食物中毒發(fā)病率為96%,病死率高達68%~89%,個別中毒事件死亡率甚至達到100%。BGC也在東南亞、非洲部分地區(qū)引起食物中毒 (西方國家未見報道) 。
BGC引發(fā)的食物中毒常見于家庭自制的酵米面、糯米粉、吊漿粑等,被BGC污染而變質(zhì)的市售木耳、銀耳、河粉等也能引起食物中毒。

本次食物中毒事件中,制作酸湯子的原材料是玉米面,需要用水長時間浸泡 (氣溫低浸泡1個月,氣溫高浸泡10天) ,成糊狀水面后用布兜起濾出多余水分,制作過程中很容易受病菌、真菌污染,產(chǎn)生毒性。
因此,《遼寧省食品藥品監(jiān)督管理局2015年第2期食品安全提示公告》中提出:盡量廢除酵米面食物這種陳舊不良的飲食習(xí)慣。
和黃曲霉毒素一樣,米酵菌酸也是強耐熱毒素,其毒性在120℃高溫下1小時仍不被破壞,難以被普通的家庭烹飪方式消滅。
那食物中毒時我們該怎么辦?
如應(yīng)對食物中毒?
我們先了解一下什么是食物中毒。食物中毒又稱“食源性疾?。╢oodborn diseases) ”。
依據(jù)2002年WHO對“食源性疾病”的定義,只要是通過食物使病源物質(zhì)進入人體內(nèi)并引起的疾病都被認為是食源性疾?。òㄊ吃葱阅c道傳染病、食源性寄生蟲病、變態(tài)反應(yīng)性疾病及暴飲暴食引起的急性胃腸炎等) 。
食物中毒主要分六大類:
1.細菌性食物中毒(沙門菌屬、志賀菌屬、金黃色葡萄球菌等)
2.化學(xué)性食物中毒(有機磷農(nóng)藥、殺鼠劑、瘦肉精等)
3.動物性食物中毒(河豚、有毒貝類、雪卡毒素等)
4.植物性食物中毒(桐油、木薯、苦杏等)
5.真菌性食物中毒(黃曲霉毒素)
6.致病物不明的食物中毒(學(xué)術(shù)上中毒物質(zhì)尚不明的食物)
無論哪種形式的食物中毒,只要有人出現(xiàn)惡心、上腹不適、嘔吐、腹瀉、全身無力等癥狀,要立即停止食用可疑食品;盡快催吐,排出胃內(nèi)容物,減少毒素吸收及機體損傷;采集可疑食品或患者嘔吐物標本送檢化驗,有助于醫(yī)生對病情的判斷;及時送醫(yī)洗胃、清腸、對癥治療。
關(guān)于食物中毒,預(yù)防重于治療。

在購買食品時盡量選擇小袋密封包裝食品,大袋子要用密封夾封緊,防止食物霉變;注意食物的保質(zhì)期,不要長時間存放;糧油、堅果、調(diào)味劑應(yīng)在低溫、通風(fēng)、干燥環(huán)境保存;保持廚房環(huán)境及容器清潔,定期消毒;對于需要發(fā)泡木耳、銀耳、蘑菇等干貨,泡發(fā)前要先洗凈,密封后置于冰箱冷藏室泡發(fā),時間不可超過24小時;干貨泡發(fā)后,如產(chǎn)生異味或表面黏膩應(yīng)馬上丟棄。
像酸湯子這種可以產(chǎn)生有毒物質(zhì)的食品丟棄時,是算廚余垃圾還是有害垃圾呢?
參考資料:
林果為, 王吉耀, 葛均波. 實用內(nèi)科學(xué)(上)[M]. 人民衛(wèi)生出版社, 2017.
譚知顯. 黃曲霉菌的毒性測定[J]. 微生物學(xué)通報, 1981(06):33-35.
勞文艷, 林素珍. 黃曲霉毒素對食品的污染及危害[J]. 北京聯(lián)合大學(xué)學(xué)報(自然科學(xué)版), 2011, 25(001):64-69.
彭子欣, 李鳳琴. 唐菖蒲伯克霍爾德菌米酵菌酸生物合成機制[J]. 衛(wèi)生研究, 2020(2).